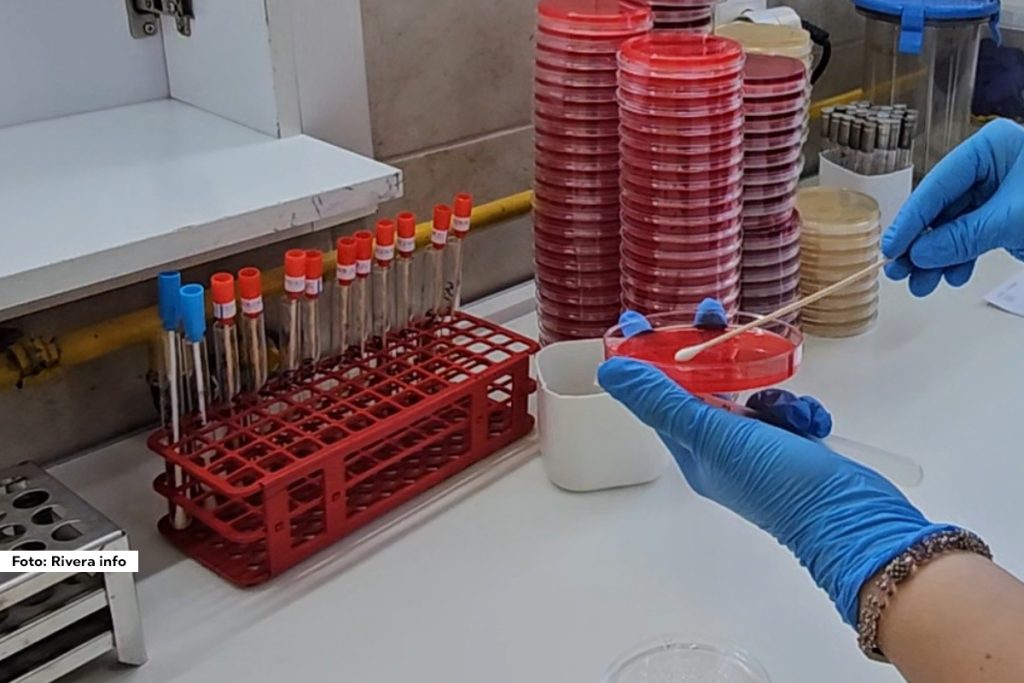
U Mačvanskom okrugu potvrđena su dva slučaja sezonskog gripa, jedan u Vladimircima gde je virus gripa potvrđen kod dvogodišnjeg deteta i jedan slučaj u Šapcu kod osobe starosti 70 godina.

U Mačvanskom okrugu potvrđena su dva slučaja sezonskog gripa, jedan u Vladimircima gde je virus gripa potvrđen kod dvogodišnjeg deteta i jedan slučaj u Šapcu kod osobe starosti 75 godina.
Dr Slađana Hadživuković Stojanović iz Zavod za javno zdravlje Šabac kaže da oba slučaja nisu bila vakcinisana i zbog toga je uputila apel da se ljudi vakcinišu, jer je vakcina jedna od najbezbednijih i najdelotvornijih načina prevencije, kako kolektivnog tako i individualnog imuniteta.
– Što se tiče ova dva slučaja, oba su potvrđena na našem institutu na Torlaku. Kod nas u Mačvanskom okrugu, u ovoj sezoni vakcinisano je preko 15.000 ljudi i naglasila bih da je u Domu zdravlja “Dr Draga Ljočić” vakcinisano preko 98% stanovništva.

Foto: Rivera info
Mogu da se vakcinišu svi, kako deca tako i odrasli. Mogu da se vakcinišu deca preko šest meseci i odrasli do 65 godina, s tim što bih apelovala na one koji su po nekom osnovu posebno ugroženi, kao što su trudnice, starije osobe, hronični bolesnici koji nisu u mogućnosti da se vakcinišu, ali njihovi ukućani bi to obavezno trebali da učine – izjavila je dr Slađana Hadživuković Stojanović.
Rivera info